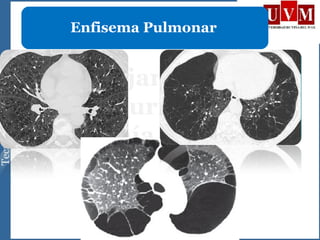
Enfisema Pulmonar

Este documento describe varias enfermedades y patrones pulmonares radiológicos. Describe lesiones alveolares como neumonía, atelectasias y enfisema, así como patrones intersticiales, nodulares y de atenuación pulmonar. Explica cómo la tomografía computarizada de alta resolución puede identificar enfermedades pulmonares intersticiales, fibrosis pulmonar y bronquiectasias.